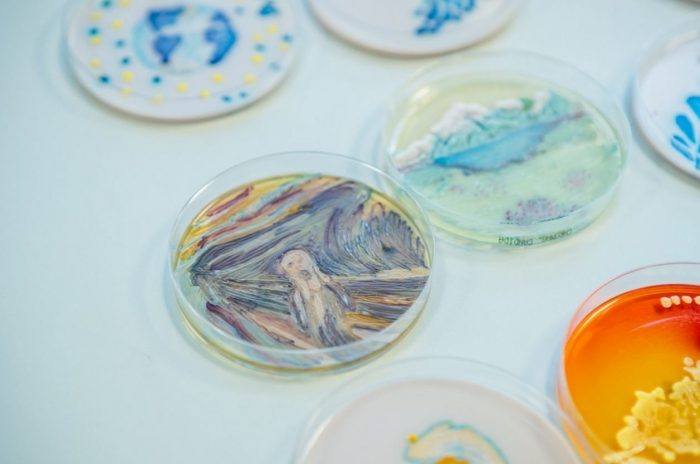

Két magyar szakember is díjat kapott az Amerikai Mikrobiológusok Társaságának idei versenyén az Agar Art-on, mikrobákból alkotott festményeikért.
Két magyar szakember is díjat kapott az Amerikai Mikrobiológusok Társaságának idei versenyén az Agar Art-on, mikrobákból alkotott festményeikért. A mikrobákból nevelt magyar népművészeti mintával Pöstényi Zita, a SYNLAB Hungary Kft. szakembere nyert közönségdíjat, kollégája, Héjja Andrea, aki harmadik helyet ért el a nemzetközi versenyen, Munch Sikoly című képét reprodukálta színes baktériumokból – közölte az esemény kommunikálásával megbízott ügynökség szerdán az MTI-vel.

A SYNLAB Hungary Kft. szakembereinek munkáit 347 kompozícióból választották ki, a versenyre 43 ország mikrobiológusai neveztek.
Az Agar Art lényege, hogy a mikrobiológusok vászon helyett Petri-csészét, festék helyett pedig élő organizmusokat – baktériumokat, gombákat – használnak. A versenyt 2015 óta rendezi meg az amerikai társaság, hogy megmutassa, a tudomány és a művészet nem is áll olyan távol egymástól. A versenyre idén 415 tudós és tudóscsoport összesen 347 kompozíciót nevezett be – 43 különböző országból, valamint 22 amerikai tagállamból.
A mikróbák számára a megfelelő táptalajt az agar nevű zselésítőanyaggal hozzák létre, innen kapta nevét a nemzetközi verseny.
A versenyen három kategóriában nevezhettek a kutatók: profi, félprofi és gyerek kategóriában is vártak alkotásokat a szervezők. A nemzetköz verseny legszebb műalkotását profi kategóriában az Oakland Egyetem hallgatója, Arwa Hadid készítette, aki egy Koi halat festett meg Petri-csészében.
